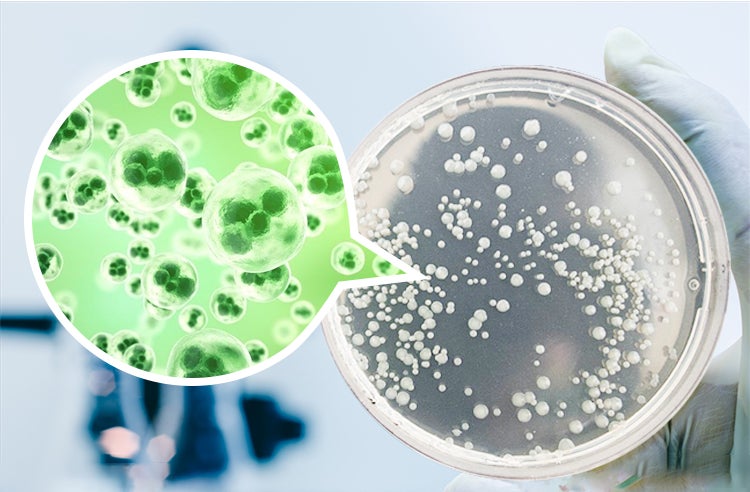

あなたのその歯ブラシ、本当に清潔ですか・・・?
必ず毎日使用する歯ブラシ、お手入れは正しくできていますか?“正しいお手入れ”ができていない歯ブラシは、一晩で約18,000個の菌が繁殖すると言われています。
× 毎回しっかり除菌ホルダーに保管しているから大丈夫
× 一つのスタンドに家族全員の歯ブラシをまとめて保管している
× 毛先が触れあわないようにキャップをして保管している
× 使用するとき毛先がまだ乾ききっていない
そんな方は要注意!歯ブラシは洗浄・除菌は兎も角、乾燥までしっかり行ってこそ、ようやく“正しいお手入れ”なのです。
菌が繁殖した歯ブラシを使用しての歯磨きは、まったくの逆効果。虫歯や口臭など、さまざまなお口トラブルの原因となってしまいます。



歯ブラシの“正しいお手入れ”手順をぎゅっと凝縮!
除菌から乾燥まですべてを行う歯ブラシホルダー「M01」
UV-C紫外線+ブルーライト光触媒によるダブル除菌で、除菌率は99.9%。さらにはサイクロンファンを搭載。除菌のみならず、乾燥まで抜かりなくお手入れできるのがこの「M01」自慢の最大特長です。
正面のデジタルディスプレイには除菌パーセンテージが表示されるので、除菌状態が目に見えて安心感も抜群。バッテリー残量・室内温度も表示され、あると便利な機能が満載!USB Type-C充電式で、何度でも繰り返しの使用OK。
強力除菌だけの歯ブラシホルダーでは物足りない!さまざまな便利機能がプラスされた、一歩先をゆくスマートな歯ブラシホルダー「M01」で、歯ブラシのお手入れをより完ペキに近づけましょう。
※一部、画像・動画に歯磨き粉ディスペンサーが掲載されておりますが、本製品には付属しません。予めご了承くださいますようお願いいたします。


「M01」は、病院などでも数多く応用されている紫外線除菌を採用。中でも強い除菌効果を持つUV-C(波長200~275nm)で、除菌率は99.9%を実現!さらに、ブルーライトの光触媒で除菌をサポート。UV-C紫外線を浴びることで、除菌を促進してくれる働きを持ちます。

歯磨きが終わったら歯ブラシを収納して、カバーを閉めるだけでOK。3分間じっくり歯ブラシに付着した菌を除菌してくれます。除菌の開始も終了も自動なので、手間がかからないのも魅力の一つ。
※除菌中のライトは直視しないでください。
▲これは歯磨き後の歯ブラシを水洗いして、24時間放置した様子。菌が繁殖しているのがよく分かります…。

▲「M01」で除菌・乾燥した歯ブラシを、除菌効果を実証できる機構で実証実験しました。結果は、大腸菌(上)99.99%、黄色ブドウ球菌(下)99.98%除菌!毎日使用する歯ブラシをより安心してご使用いただけます。

UV-C紫外線を遮断するものは無し。360°から死角なく強力除菌を促し、どこを取っても清潔な歯ブラシに仕上げます。



歯ブラシのお手入れで、意外と見落としてしまうのが“乾燥”。
例えば梅雨の時期の洗濯もの。高湿度でなかなか乾かず、生乾きの洗濯ものはどうしてもにおいが気になってしまいますよね。原因は乾燥できずに菌が繁殖してしまう為。つまり、歯ブラシにも同様なことが起こっています。さらに毛先の水分が滴り落ちると、持ち手まで菌だらけに・・・。
そこで「M01」は、サイクロンファンを搭載!除菌との同時進行で、3分間の“乾燥”を実施。濡れた状態での放置を最小限に抑え、菌の繁殖を防ぎます。


3分間の除菌乾燥では物足りない方には、しっかり乾燥モードがおすすめ!操作ボタン約2秒間の長押しで、20分間かけてゆっくりと歯ブラシを徹底的に乾燥してくれます。


本体正面に設置されたデジタルディスプレイも「M01」の大きな特長です。目には見えない除菌効果を、数字として表示してくれてとても安心。

除菌効果もほかにも、バッテリー残量・室内温度もアイコンと数字で表示してくれます。
バッテリーアイコンと数字が点滅している場合は、バッテリーが残り10%以下の合図。室内温度を表示する場合は、操作ボタンを2回プッシュすることで切り替え可能です。


1200mAhを二つ内蔵することで、コンパクトな本体に2400mAhの大容量バッテリーを実現!フル充電時間約5時間で、約1か月間の連続使用が可能です。
※毎日平均15分間使用した場合のデータです。使用状況や環境によって異なる可能性がございます。

「M01」の充電方法はUSB Type-C充電。付属の充電ケーブルを使用して、モバイルバッテリーやあらゆるUSBポートから充電してください。充電しながらの使用にも対応!

■洗面所の邪魔をしないコンパクトサイズ

なにかとモノが増えがちな洗面所。大切な除菌アイテムとは言え、大きすぎると実用性に欠けてしまいます。
「M01」はコンパクトな約横200mm×縦72mm×厚さ43mm。重さは310g。このサイズ感で、歯ブラシ5本を収納することができます。

ブラシ幅が横23mm、縦35mm以下、ブラシ下部が8mm以下の歯ブラシを収納することができます。電動歯ブラシにもサイズが合えば問題なくご使用いただけます。
■仕切りは簡単に取り外し可能、水洗いOK

直接歯ブラシに触れる可能性のある仕切り部分は、上に押し上げるだけで簡単に取り外し可能。水洗いすることが出来、衛生面も安心です。約1ヶ月間に1回、洗浄することをおすすめします。
■ホコリの侵入を防ぐ、スライド式の防塵カバー

軽く指でスライドするだけで滑らかに移動する防塵カバーの搭載で、空気中のホコリの侵入を防ぎます。
※歯磨き粉ディスペンサーは付属しません。





※ご使用にあたっての注意事項
・壁掛けフックを使用する場合、粘着テープを貼り付けてから24時間後に本体を取り付けてください。すぐに取り付けるとしっかり固定されておらず、落下する恐れがございます。
・除菌中のLEDライトは直視しないようにご注意ください。
・本体の耐荷重量は約1kgです。収納物が1kg以上にならないようご注意ください。また、重さ問わず本体の上に物を置かないでください。
・本体は防水ではありません。水がかからないようにご注意ください。
・充電する際は必ず付属のUSB Type-C充電ケーブルをご使用ください。
・仕切りは取り外し可能です。約1ヶ月に1回洗浄することをおすすめします。
・万が一故障した場合、ご支援者様ご自身での解体・修理は大変危険ですのでお止めください。



■2020年7月 クラウドファンディング開始
■2020年9月 クラウドファンディング終了
■2020年11月 日本国内発送予定

歯ブラシホルダー「M01」をレビューしてみたいというメディア様、インフルエンサー様を募集しています♪
■応募方法
メールのタイトルに「歯ブラシホルダー「M01」 レビュー希望」と記載し、下記アドレスまでご連絡ください。本文には、簡単な自己紹介をお願い致します。
メールアドレス:reception@sinsankai.co.jp
■当選者様にご協力いただく内容
商品サンプルの発送をもって当選者の発表といたします。
当選者様には、商品サンプル到着後2週間をめどに、活動されているソーシャルメディアで商品レビューを公開していただきます。
お気楽にご連絡いただければ、弊社としても嬉しい限りです。沢山のご応募お待ちしております。どうぞ宜しくお願い致します。

Q.安全ですか?
A.人体に悪影響はありませんので安全です。但し、除菌中のライトを直視しないようにご注意ください。
Q.除菌の操作はどのようにしますか?
A.歯ブラシを収納し、カバーを閉めたら自動で除菌がはじまります。除菌完了後は自動で停止し、電源がオフになりますので特に操作は必要ありません。
Q.フル充電で何日持ちますか?
A.フル充電約5時間で約480分。1日平均15分間使用した場合、約1ヶ月間ご使用いただけます。
Q.水洗いできますか?
A.本体は防水ではありませんので、水洗いは出来ません。中の仕切りは水洗い可能です。約1か月間に1回洗浄することをおすすめします。
Q.歯ブラシ以外にも使用できますか?
A.本体に収納できるサイズであれば使用可能です。
Q.返金や保証期間について
A.本製品は1年間の保証期間を設けております。取扱説明書に従った使用状態での商品不良に対して、当社にて送料を負担した上で商品の交換対応を行います(お客様の故意・過失等で生じた故障は除きます)。
※並行輸入品(保証対象外)にご注意ください。
本製品は弊社が代理店となり、正規輸入品として進めております。しかし、並行輸入品や個人輸入による販売については防ぐことが難しく、その品質について当社では保証いたしかねます。ご理解のほどよろしくお願い申し上げます。

みなさま、こんにちは。「AFUストア」と申します。
わたしたちは、みなさまに素晴らしい商品をお届けしたいという想いから、2017年にクラウドファンディング事業を立ち上げました。
2020年2月までの実績として、国内の大手クラウドファンディング運営サイトを通じて128件のプロジェクトの立ち上げ、総額5.5億円のご支援を達成しております。何れも日本のクラウドファンディング業界の実行者として1位の記録です。
個々のプロジェクトについても、1億円を達成した「Warm Geek」をはじめ、国内のクラウドファンディングの傘部門では 1~3位、掃除機部門では1、2位をそれぞれ独占、アウターやモバイルバッテリーなど多数のプロジェクトが1,000万円を超えるとともに、様々なメディアにも取り上げられています。

最新の活動報告
もっと見るリターン商品発送完了のお知らせ。
2020/11/16 13:53こちらの活動報告は支援者限定の公開です。配送先住所のご確認をお願いします。
2020/10/30 16:29こちらの活動報告は支援者限定の公開です。仕様変更に関するお知らせ
2020/10/28 12:27こちらの活動報告は支援者限定の公開です。





コメント
もっと見る